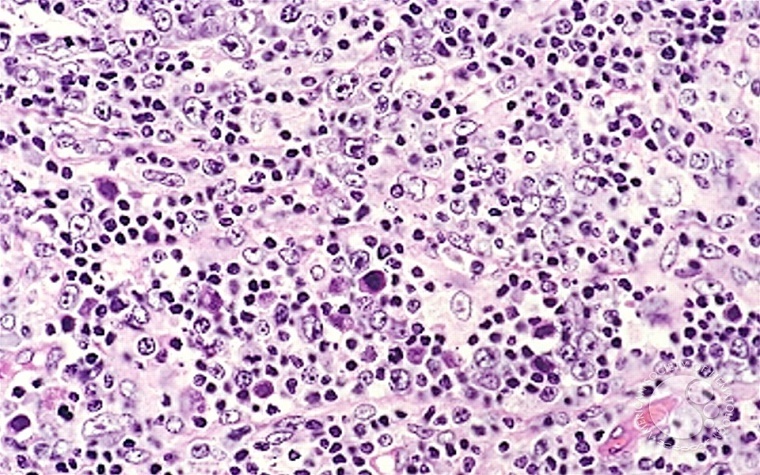

AbbVie entered four new collaborations this month that will focus on oncology, immunology and genomics.
"We can develop tomorrow's most important therapies by investing in today's leading technologies and scientific achievements," AbbVie Executive Vice President Dr. Michael Severino said. "Combining the strengths of AbbVie's discovery and development expertise and novel research from external partners will accelerate the pace of innovation into new medicines for the next-generation of medical treatment."
A research and license agreement between AbbVie and Pure MHC, a privately held target discovery company, will validate peptide targets for use with T-cell receptor therapeutics in several different cancers.
Zebra Biologics, a discovery-stage biotechnology company, and AbbVie are in partnership with hope to discover agonist antibody therapeutics for inflammatory diseases. Zebra has a novel and patented function-based antibody discovery platform that will be used to activate biological pathways associated with AbbVie designated targets.
Genomics Medicine Ireland, a life sciences startup company in Ireland, is partnering with AbbVie to conduct population genomics research in 45,000 Irish volunteers. The goal of the collaboration is to understand human biology and disease etiology for new therapies and to identify biomarkers.